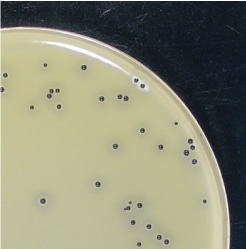
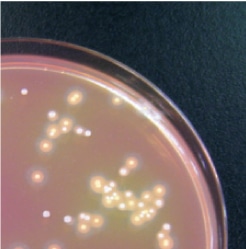

食品微生物検査の手順
(黄色ブドウ球菌)
使用培地
| 旧 | 新 | |
| 試料調製 | 滅菌リン酸緩衝液 (90mlまたは225ml) |
緩衝ペプトン水 (BPW)225ml |
| 培地接種 | RV培地、TT培地 | 卵黄加ベアード パーカー寒天培地又は卵黄加マンニット 食塩寒天培地 |
<前処理>
試料25gを秤量し、緩衝ペプトン水225mlを加え、1~2分、ホモジナイズします。※必要に応じて、100倍希釈液、1,000倍希釈液を作製する。

<培養>
2枚の卵黄加ベアードパーカー寒天培地あるいは、卵黄加マンニット食塩寒天培地に、それぞれコンラージ棒で0.1ml塗抹する。 15分間乾燥させた後、平板を逆さにして培養する。
<判定>
ベアードパーカー:周囲に透明帯が存在する、黒または灰色で、光沢のある隆起した円形集落を指す。
<確認試験>
①純培養:疑わしい集落を1平板につき2~5個釣菌し、トリプトケースソイ寒天(TSA)培地に塗抹し、37℃で22±2時間培養。②同定
・グラム染色を行う→グラム陽性の球菌
・コアグラーゼ試験
市販のウサギプラズマの容器に滅菌生理食塩水7mlを加え、溶解し、小試験に0.5mlずつ分注する。
純培養した集落を白金耳で釣菌し、その1白金耳量をウサギプラズマ0.5mlに接種する。


2、35±1℃で保温4時間(30分間隔)・6時間・24時間凝固が認められるまで観察。
(+)全体凝固・部分凝固
(-)22±2時間後に判定。
微生物検査を始めたい企業様へ

食品微生物検査キットDDSマスターⅢは、微生物検査に必要な機器を取り揃えた初歩的なキットです。
D(どこでも)、D(誰でも)、S(すぐできる)の名の通り、初めての方でも簡単に微生物検査が行えます。
このセットを使用すれば限られたスペースでも自主検査(微生物検査)がスタートできます。
※DDSキットは5~10検体/日の検体数を目安にしております。
それ以上の検体数や、検査する対象の菌種が多岐にわたる場合、ご相談ください。



